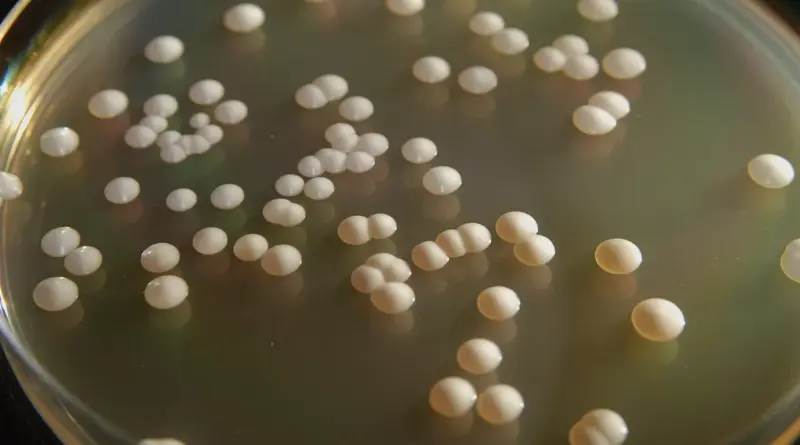

Bioenergía: Autorizan el uso de nuevas levaduras que podrían aumentar la producción de Etanol
Son variedades genéticamente modificadas para optimizar el procesamiento de carbohidratos y granos, que podrían llevar la producción hasta los 24 millones de litros anuales.
Leer más